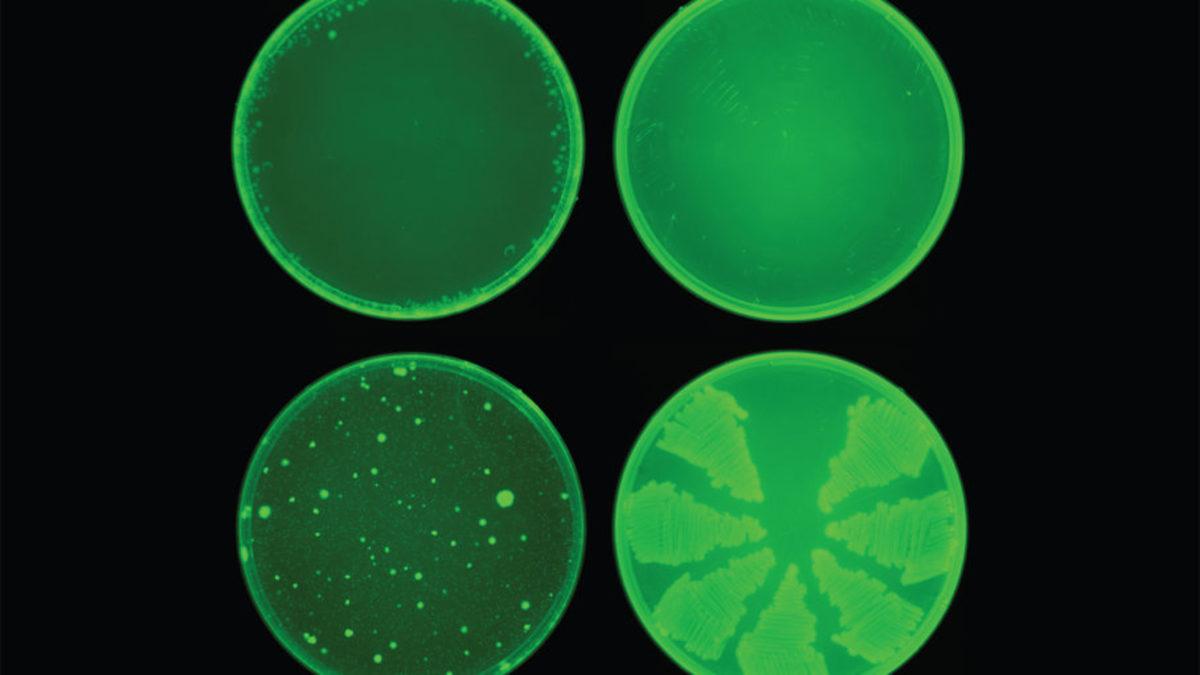
Bilim İnsanları, Yapay Zekâyla Rekor Sürede Antibiyotik Keşfetti

Sir Alexander Fleming adında bir İskoç bilim insanı, 1928 yılında stafilokok bakterilerini incelediği laboratuvarından ayrıldı ve ailesiyle birlikte iki haftalık bir tatile çıktı. Fleming, laboratuvara döndüğünde sadece çalışma alanını çok iyi düzenlemediğini değil, içinde bakteri bulunan yemeklerin küflendiğini gördü. Ayrıca bakterilerin hücre kültür kabının küflü alanlarından aktif olarak kaçınıyor gibi göründüğünü fark etti.
Tüm bu yaşananlardan sonra Fleming, “Dünyanın ilk antibiyotik veya bakteri öldürücüsünü keşfederek tüm ilaçlarda devrim yapmayı planlamamıştım. Sanırım tam da bunu yaptım” dedi. Bu günlerdeyse yeni antibiyotikleri keşfetmek dikkatsiz ve ihmalkâr bir bilim insanı gerektirmiyor.
Antibiyotik keşfinde yapay zekâ kullanıldı:
MIT'de çalışan bir grup araştırmacı, antibiyotiğe dirençli yapıları bile öldüren yeni bir antibiyotiği keşfetmek için yapay zekâ kullandı. Araştırma ekibi, sadece birkaç gün içinde yüz milyondan fazla kimyasal bileşiği sistematik olarak tarayan bir bilgisayar modeli oluşturdu.
MIT’den Profesör James Collins, “Antibiyotik direnci etrafında büyüyen bir krizle karşı karşıyayız. Bu durum mevcut antibiyotiklere dirençli hâle gelen patojenlerin sayısıyla ortaya çıkıyor” diyor. Araştırma ekibi, bakterilerin büyümesini engelleyen yaklaşık 2.500 moleküler bileşiği tanımlayabilen bir makine öğrenimi modeli geliştirdi.
Bilim insanlarından antibiyotik çalışması:

Program, bilinen insan hastalıklarının iyileştirilmesinde faydalı olup olmadığını görmek için hâlihazırda incelenmekte olan 6.000 ilaca tanıtıldı. Model, bilinen herhangi bir antibiyotiğe benzemeyen en güçlü antibakteriyel potansiyele sahip molekülü seçtikten sonra ekip, molekülün insanlara zarar verip vermeyeceğini görmek için farklı bir model kullandı.
Model, adayları bire indirdi. O da araştırmacıların 'halisin' olarak adlandırdığı kimyasal bileşendi. Halisin, başlangıçta diyabet tedavisi için araştırılmış ancak testteki zayıf sonuçlardan dolayı bu araştırma devam etmemişti.
Halisinin keşfedilmesinden sonra araştırma ekibi, modeli başka bir bileşik veritabanı kullanarak 23 aday daha tanımladı ve bunlardan iki tanesi güçlü çıktı. Araştırmacılar şimdi bakterilerde daha seçici olan antibiyotikler bulmak için çalışıyorlar ve bunu yaparken tüm yararlı bağırsak floramızı koruyorlar. Halisine gelince araştırmacılar, ilacı insanlarda kullanmak üzere geliştirmek için bir ilaç şirketi veya kâr amacı gütmeyen kuruluş ile çalışmayı planlıyorlar.
